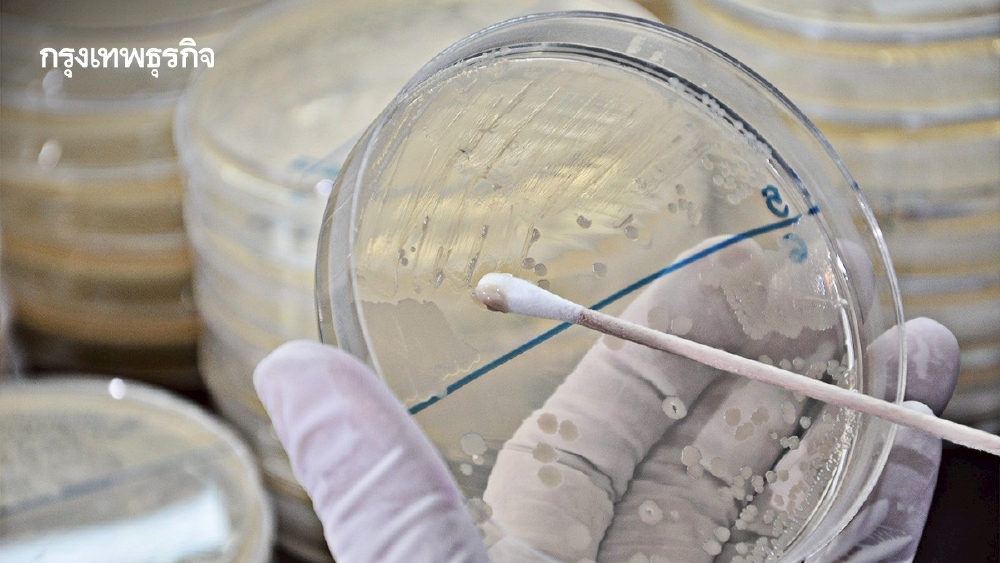
.ปี 68 สุ่มตรวจ 'ยาดม' 54 ตัวอย่างพบผิดมาตรฐาน 39 ตัวอย่าง.

5 อาหารที่คนเข้าใจผิดคิดว่า "ดีต่อสุขภาพ" แต่จริงๆ แล้วอาจส่งผลเสียต่อร่างกาย
.jpg?ip/crop/w1200h700/q80/jpg)
เชฟเมืองนอก เตือน 5 อาหารที่หลายคนคิดว่าดีต่อสุขภาพ แต่แท้จริงกลับไม่ดีอย่างที่คิด
บ่อยครั้งที่เราเลือกรับประทานอาหารโดยเชื่อตามชื่อเสียงว่า "ดีต่อสุขภาพ" แต่ผู้เชี่ยวชาญด้านอาหารได้ออกมาเปิดเผยว่า อาหารยอดนิยมบางชนิดที่เรากินอยู่เป็นประจำนั้น อาจไม่ได้ดีต่อร่างกายอย่างที่คิด ซึ่งอาจทำให้ความตั้งใจในการดูแลสุขภาพของเราต้องสับสน
ปัจจุบันผู้คนหันมาใส่ใจกับการรับประทานอาหารมากขึ้น แต่ถึงแม้จะตระหนักถึงอาหารที่มีโซเดียมหรือน้ำตาลสูง อาหารบางอย่างที่ดูดีมีชื่อเสียงก็อาจหลอกให้เราเข้าใจผิดว่าต้องกินเป็นประจำ เชฟ Jimmy Chill หัวหน้าเชฟของร้าน Olea & Bloom ในฟลอริดา ได้ให้ความเห็นที่น่าสนใจกับ New York Post เกี่ยวกับสิ่งที่ "ดีต่อสุขภาพ" ที่แท้จริง
เชฟ Chill ซึ่งมีประสบการณ์ในการทำอาหารเพื่อสุขภาพและโภชนาการกล่าวว่า "จากประสบการณ์หลายปีในการเป็นเชฟที่เชี่ยวชาญด้านเมนูที่เน้นสารอาหาร ผมได้เห็นกับตาว่าคำโฆษณาทางการตลาดเกี่ยวกับ "อาหารสุขภาพ" สามารถทำให้การกินเพื่อสุขภาพกลายเป็นเรื่องที่เข้าใจยากได้อย่างไร"

1. อาซาอิโบวล์ (Açaí bowls)
อาซาอิโบวล์กลายเป็นอาหารยอดนิยมอย่างรวดเร็ว เนื่องจากผู้คนมองว่าเป็นตัวเลือกอาหารเช้าที่ดีต่อสุขภาพ ส่วนประกอบหลักคือเบอร์รีอาซาอิบดและผลไม้แช่แข็งอื่น ๆ ซึ่งตัวส่วนผสมหลักนั้นไม่ใช่ปัญหา แต่ปัญหาอยู่ที่ท็อปปิ้งที่ใส่เพิ่มเข้าไปในโบวล์ต่างหาก
เชฟ Chill อธิบายว่า “เมื่อคุณเติมกราโนลา ผลไม้ และน้ำผึ้ง ซูเปอร์ฟู้ดนี้ก็จะกลายเป็นระเบิดน้ำตาลที่จะทำให้ร่างกายคุณอ่อนเพลียในที่สุด” เขาแนะนำให้หลีกเลี่ยงอาซาอิโบวล์ที่ซื้อจากร้านหรือคาเฟ่ แต่ควรทำเองโดยใช้ผลอาซาอิบริสุทธิ์ 100 เปอร์เซ็นต์เท่านั้น
2. ผักอบกรอบ (Veggie Chips)
หลายคนชอบกินผลิตภัณฑ์มังสวิรัติแปรรูป หรือ ผักอบกรอบ เพราะเคี้ยวเพลินและอร่อย แต่ถึงแม้จะเป็นอาหารที่ทำจากพืช ก็ไม่ได้หมายความว่ามันจะ "ดีต่อสุขภาพ" ไปโดยปริยาย เชฟ Chill ระบุว่า “อาหารที่ทำจากพืชไม่ได้หมายความว่าจะดีต่อสุขภาพเสมอไป”
“ผลิตภัณฑ์จากพืชจำนวนมากทำจากส่วนผสมที่สร้างขึ้นในห้องปฏิบัติการและผ่านการแปรรูปอย่างมาก” เชฟยังเสริมอีกว่าอาหารเหล่านี้ “ไม่มีคุณค่าทางโภชนาการจากผักเลย” และกระบวนการปรุงอาหารมักทำให้ “สารอาหารสูญหายไป” อย่างสิ้นเชิง
3. เครื่องดื่มโปรตีนสำเร็จรูป (Protein Shakes)
ในช่วง 2-3 ทศวรรษที่ผ่านมา ผู้คนให้ความสำคัญกับการออกกำลังกายและเพิ่มปริมาณโปรตีนมากขึ้น แต่การบริโภคเครื่องดื่มโปรตีนบางชนิดก็มีข้อเสีย เชฟ Chill อธิบายว่า “เครื่องดื่มโปรตีนเหล่านี้มักถูกระบุว่าเป็นอาหารทดแทนหรือตัวเลือกสำหรับการลดน้ำหนัก”
เครื่องดื่มเหล่านี้มีส่วนผสมที่มีความเข้มข้นสูง เช่น โปรตีนถั่วเหลือง หรือโปรตีนนมแยกส่วน เพื่อให้ได้โปรตีน "ต่อหน่วยบริโภค" สูงตามที่ระบุไว้ นอกจากนี้ ยังมักมีสารให้ความหวานเทียมและสารปรุงแต่งอื่น ๆ ซึ่งสามารถทำลายจุลินทรีย์ในลำไส้ ส่งผลกระทบต่อระบบย่อยอาหาร และแม้กระทั่งความชัดเจนทางความคิด

4. น้ำมันมะกอก (Olive oil)
น้ำมันมะกอกมีชื่อเสียงด้านประโยชน์ต่อสุขภาพ เนื่องจากมีไขมันไม่อิ่มตัวเชิงเดี่ยว สารต้านอนุมูลอิสระ เช่น โพลีฟีนอล และสารต้านการอักเสบต่าง ๆ อย่างไรก็ตาม เชฟ Chill เปิดเผยว่าปัญหาหลักนั้นง่ายมาก: “แม้ว่าน้ำมันมะกอกจะมีไขมันที่ดีต่อหัวใจ แต่สิ่งสำคัญที่สุดคือ การควบคุมปริมาณ”
ผู้เชี่ยวชาญเน้นย้ำว่า “น้ำมันทุกชนิดไม่ได้ถูกสร้างขึ้นมาเท่ากัน” และชี้ให้เห็นว่าน้ำมันบางชนิดมีปริมาณแคลอรีที่สูงกว่าชนิดอื่น ๆ ดังนั้นจึงต้องระมัดระวังในการใช้งาน

5. สมูทตี้และน้ำดีท็อกซ์ (Smoothies and detox juices)
เครื่องดื่มเหล่านี้เป็นอีกหนึ่งกระแสที่ได้รับความนิยมอย่างรวดเร็ว โดยเฉพาะบนโซเชียลมีเดีย แต่ก็มีข้อเสียอยู่เช่นกัน เชฟ Chill ถึงกับกล่าวว่า "ไม่มีความจำเป็น" สำหรับน้ำดีท็อกซ์ตั้งแต่แรก เพราะร่างกายที่แข็งแรงจะทำการดีท็อกซ์ "ด้วยตัวมันเอง"
เขายังชี้ให้เห็นว่าสมูทตี้หลายชนิดมีแคลอรีสูงมากอีกด้วย เชฟ Chill กล่าวว่า “เช่นเดียวกับผักอบกรอบ การปั่นผลไม้สามารถทำให้สารอาหารลดลง และตัวเลือกที่ซื้อจากร้านค้าส่วนใหญ่มักผ่านการพาสเจอไรซ์ ซึ่งลดความสดใหม่ลงไป”
ดังนั้นทุกอย่างควรอยู่ในปริมาณที่พอเหมาะ และเราไม่ควรหลงเชื่อการตลาดของบริษัทต่าง ๆ ที่โฆษณาชวนเชื่อเกี่ยวกับ "ซูเปอร์ฟู้ด" เพื่อสุขภาพมากเกินไป
ที่มา : 5 อาหารที่คนเข้าใจผิดคิดว่า "ดีต่อสุขภาพ" แต่จริงๆ แล้วอาจส่งผลเสียต่อร่างกาย
.jpg?ip/crop/w1200h700/q80/jpg)